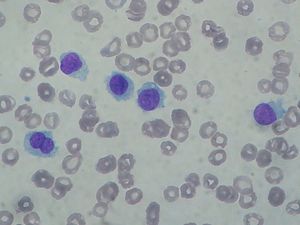

ابيضاض خلايا الدم المشعرة
| Hairy cell leukemia | |
|---|---|
 | |
| التخصص | علم الدم و علم الأورام |
ابيضاض خلايا الدم المشعرة أو سرطان الدم ذو الخلايا المشعرة إنگليزية: Hairy cell leukemia هو مرض دموي خبيث نادر يتميز بتراكم الخلايا اللمفاوية البائية بشكل غير طبيعي.[1] وعادةً ما يصنف كنوع فرعي من سرطان الدم الليمفاوي المزمن (CLL). سرطان الدم ذو الخلايا المشعرة يشكل حوالي 2٪ من جميع حالات سرطان الدم، مع تشخيص أقل من 2,000 حالة جديدة سنويا في أمريكا الشمالية وأوروبا الغربية مجتمعة.
تكون الخلايا البائية تلك غير طبيعية وتبدو "مشعرة" تحت المجهر. ومع زيادة خلايا سرطان الدم، يتم إنتاج كميات أقل من خلايا الدم البيضاء، وخلايا الدم الحمراء، والصفيحات.[2] يصيب سرطان الدم المشعر الخلايا الرجال أكثر من النساء، ويكون أكثر شيوعًا لدى البالغين في منتصف العمر أو كبار السن. ويعتبر مرضًا مزمنًا لانه قد لا شفاؤه كليًا، على الرغم من أن العلاج يمكن أن يؤدي إلى تخفيف الأعراض وخمودها لسنوات.
علامات وأعراض
في سرطان الدم ذو الخلايا المشعرة، تتراكم "خلايا الشعر" (الخلايا اللمفاوية ب الخبيثة) في نخاع العظام، ومع زيادة عدد خلايا سرطان الدم، يتم إنتاج عدد أقل من كريات الدم البيضاء السليمة وخلايا الدم الحمراء والصفائح الدموية. نتيجة لذلك، قد يصاب المرضى بالتهابات مرتبطة بانخفاض عدد خلايا الدم البيضاء، وفقر الدم والتعب بسبب نقص خلايا الدم الحمراء، أو نزيف سهل بسبب انخفاض عدد الصفائح الدموية. [3] قد تتجمع خلايا اللوكيميا في الطحال وتتسبب في تضخمها؛ هذا يمكن أن يكون له تأثير جانبي على جعل الشخص يشعر بالشبع حتى عندما لا يأكل أو لا يتناول الكثير.
يتم تشخيص سرطان الدم المشعر عادةً بعد أن يظهر عدد روتيني للدم أعدادًا منخفضة بشكل غير متوقع من نوع أو أكثر من خلايا الدم الطبيعية، أو بعد كدمات غير مفسرة أو عدوى متكررة لدى مريض يتمتع بصحة جيدة.
قد يكون اختلال وظائف الصفائح الدموية لدى مرضى HCL، على الرغم من أن هذا لا يبدو أن له أي تأثير عملي كبير. [4] قد يؤدي هذا إلى حدوث كدمات خفيفة إلى حد ما أكثر مما كان متوقعًا لعدد صفيحات معين أو زيادة في وقت النزف بشكل معتدل لجرح بسيط. من المحتمل أن يكون ناتجًا عن إنتاج الصفائح الدموية غير الطبيعية قليلاً في نسيج النخاع العظمي المرهق.
قد يعاني المرضى الذين يعانون من ارتفاع الأورام من انخفاض مستويات الكوليسترول إلى حد ما، [5] خاصة عند المرضى الذين يعانون من تضخم في الطحال. [6] تعود مستويات الكوليسترول في الدم إلى قيم طبيعية أكثر مع علاج ناجح للـ HCL.
الأسباب
إن السبب الحقيقي لسرطان الدم مشعر الخلايا ليس واضحاً بشكل كامل، ولكن يعرف الأطباء أن السرطان يحدث عندما تحدث طفرات في الحمض النووي. وفي حالة سرطان الدم الخلوي، قد تتسبب الطفرات في الحمض النووي في الخلايا الجذعية لنخاع العظم، في إنتاج الكثير من خلايا الدم البيضاء التي لا تعمل بشكل صحيح. وعلى الرغم من ذلك، لم يصل الأطباء لسبب طفرات الحمض النووي التي تؤدي إلى سرطان الدم مشعر الخلايا.[7]
التشخيص
يمكن اقتراح تشخيص HCL بنتائج غير طبيعية على تعداد دم كامل (CBC)، ولكن من الضروري إجراء اختبارات إضافية لتأكيد التشخيص. عادةً ما يُظهر CBC انخفاض عدد خلايا الدم البيضاء وخلايا الدم الحمراء والصفائح الدموية لدى مرضى HCL. ومع ذلك، إذا كانت هناك أعداد كبيرة من الخلايا الشعرية موجودة في مجرى الدم، فيمكن العثور على عدد الخلايا اللمفاوية الطبيعية أو حتى عالية.
في الفحص البدني، 80-90 ٪ من المرضى لديهم الطحال منتفخ، والتي يمكن أن تكون ضخمة. [8] وهذا يكون أقل احتمالًا بين المرضى الذين تم تشخيصهم في مرحلة مبكرة. اعتلال العقد اللمفية المحيطية (تضخم العقد اللمفاوية) غير شائع (أقل من 5 ٪ من المرضى)، ولكن اعتلال عقد لمفية البطن هو اكتشاف شائع نسبيا على فحوصات التصوير المقطعي المحوسب. [8]من الممكن أيضًا تشخيص سرطان الدم المشعر بشكل نهائي من خلال قياس التدفق الخلوي على الدم أو نخاع العظم.
تشمل التشخيصات التفاضلية ما يلي: عدة أنواع من فقر الدم، بما في ذلك فقر الدم النخاعي وفقر الدم اللاتنسجي، [9] ومعظم أنواع الأورام في الدم، بما في ذلك متلازمة خلل التنسج النخاعي التنسقي، وسرطان الدم الليمفاوي المزمن غير الشائع، وسرطان الدم الليمفاوي المزمن غير المقيد للخلايا، وسرطان الدم B - خلية غير نمطية. [10]
علاج
ليس الجميع بحاجة إلى العلاج على الفور. يعطى العلاج عادة عندما تتداخل أعراض المرض مع الحياة اليومية للمريض، أو عندما تنخفض نسبة تزايد خلايا الدم البيضاء أو الصفائح الدموية إلى مستويات منخفضة بشكل خطير، مثل العدلات المطلقة التي تقل عن ألف خلية لكل ميكروليتر (1.0 ك / ماي). ليس كل المرضى بحاجة إلى العلاج فور التشخيص. لا يوجد علاج لابيضاض خلايا الدم مشعر الخلايا. إلا أن اختيارات العلاج المتاحة قادرة على وضع ابيضاض الدم مشعر الخلايا في حالة خمول لسنوات. عن طريق العلاج الكميائي الذي يعده الأطباء العلاج الأول ضد ابيضاض خلايا النسيج الدموي أو بالعلاج البيولوجي حيث العلاج البيولوجي يزيد من إمكانية تعرف جهازك المناعي على الخلايا السرطانية. وبمجرد أن يحدد جهاز المناعي الخلايا السرطانية باعتبارها دخيلة، يمكن أن يبدأ في تدمير السرطان. أو الجراحة (استئصال الطحال) خيارًا مطروحًا إذا كانت هناك تفتُّقات بطحالك، أو إذا كان متضخِّمًا، أو إذا ما تسبب بالألم. وعلى الرغم من أن إزالة الطحال لا يمكنها أن تشفي سرطان الدم بالخلايا المشعرة، فإنها يمكنها أن تعيد تعداد الكريات إلى وضعه الطبيعي. الكيميائي.
انظر أيضاً
مراجع
- ^ "Hairy cell leukemia: MedlinePlus Medical Encyclopedia". medlineplus.gov (in الإنجليزية). Retrieved 2018-04-17.
- ^ Schrek R, Donnelly WJ (February 1966). ""Hairy" cells in blood in lymphoreticular neoplastic disease and "flagellated" cells of normal lymph nodes". Blood. 27 (2): 199–211. doi:10.1182/blood.V27.2.199.199. PMID 5322749. Archived from the original on 2007-09-29. Retrieved 2007-04-20.
- ^
{{cite web}}: Empty citation (help)CS1 maint: url-status (link) - ^ Zuzel M, Cawley JC, Paton RC, Burns GF, McNicol GP (1979). "Platelet function in hairy-cell leukaemia". J. Clin. Pathol. 32 (8): 814–21. doi:10.1136/jcp.32.8.814. PMC 1145815. PMID 512041.
- ^ Pandolfino J, Hakimian D, Rademaker AW, Tallman MS (July 1997). "Hypocholesterolemia in hairy cell leukemia: a marker for proliferative activity". Am. J. Hematol. 55 (3): 129–33. doi:10.1002/(SICI)1096-8652(199707)55:3<129::AID-AJH2>3.0.CO;2-U. PMID 9256291.
- ^ Juliusson G, Vitols S, Liliemark J (July 1995). "Mechanisms behind hypocholesterolaemia in hairy cell leukaemia". BMJ. 311 (6996): 27. doi:10.1136/bmj.311.6996.27. PMC 2550084. PMID 7613319.
{{cite journal}}: Unknown parameter|تاريخ أرشيف=ignored (help); Unknown parameter|مسار أرشيف=ignored (help) - ^ Orlandi G, Fanucchi S, Strata G, Pataleo L, Landucci Pellegrini L, Prontera C, Martini A, Murri L (2000). "Transient autonomic nervous system dysfunction during hyperacute stroke". Acta Neurol. Scand. 102 (5): 317–21. doi:10.1034/j.1600-0404.2000.102005317.x. PMID 11083509.
- ^ أ ب Wintrobe, Maxwell Myer (2004). Wintrobe's clinical hematology. John G. Greer; John Foerster, John N. Lukens, George M Rodgers, Frixos Paraskevas (11 ed.). Hagerstown, MD: Lippincott Williams & Wilkins. pp. 2465–2466. ISBN 978-0-7817-3650-3.
- ^ Hairy Cell Leukemia at eMedicine
- ^ Wanko SO, de Castro C (2006). "Hairy cell leukemia: an elusive but treatable disease". علم الأورام. 11 (7): 780–9. doi:10.1634/theoncologist.11-7-780. PMID 16880237.
Table 4. Phenotypic differential diagnosis of hairy cell leukemia{{cite journal}}: External link in|quote=|تاريخ أرشيف=ignored (help); Unknown parameter|مسار أرشيف=ignored (help)
وصلات خارجية
| Classification | |
|---|---|
| External resources |